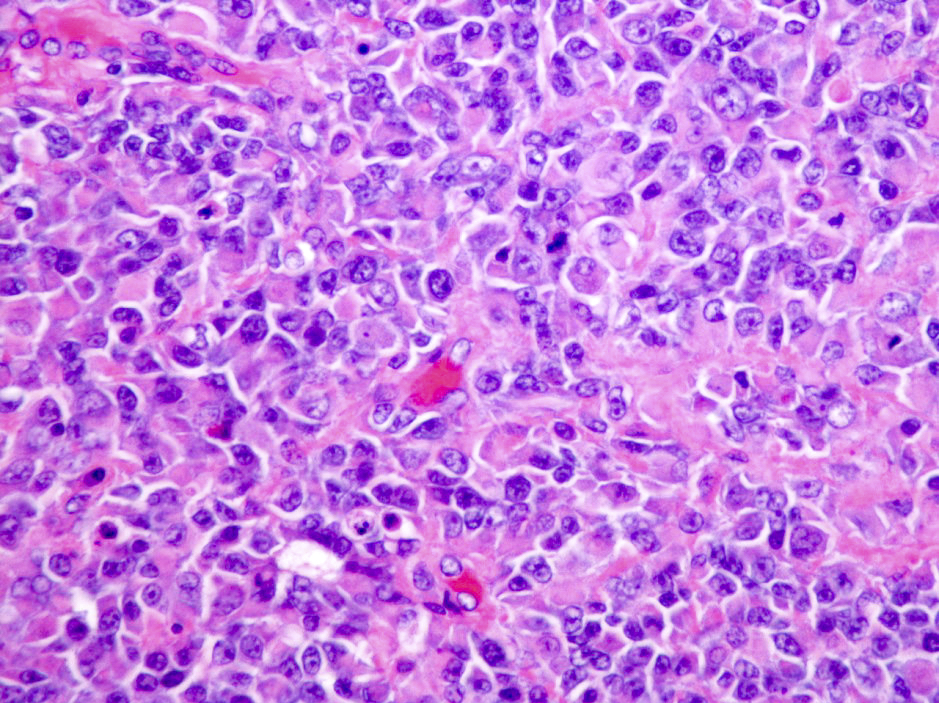

Table of Contents
Definition / general | Essential features | ICD coding | Epidemiology | Sites | Pathophysiology | Etiology | Diagrams / tables | Clinical features | Diagnosis | Laboratory | Radiology description | Radiology images | Prognostic factors | Case reports | Treatment | Gross description | Gross images | Frozen section description | Intraoperative frozen / smear cytology images | Microscopic (histologic) description | Microscopic (histologic) images | Cytology description | Positive stains | Negative stains | Electron microscopy description | Electron microscopy images | Molecular / cytogenetics description | Molecular / cytogenetics images | Sample pathology report | Differential diagnosis | Practice question #1 | Practice answer #1 | Practice question #2 | Practice answer #2Cite this page: Anderson SA, Singh N. Atypical teratoid / rhabdoid tumor. PathologyOutlines.com website. https://www.pathologyoutlines.com/topic/cnstumoratypicalteratoidrhabdoid.html. Accessed August 26th, 2025.
Definition / general
- High grade malignant CNS embryonal tumor composed of poorly differentiated cells with a variable number of rhabdoid cells
- Occurs predominantly in young children; diagnosis is based on demonstrating loss of SMARCB1 (INI1) or SMARCA4 (BRG1)
- Tumors with similar morphology but that lack characteristic molecular findings are classified as CNS embryonal tumors with rhabdoid features
Essential features
- CNS embryonal tumor with a polyimmunophenotype and loss of nuclear SMARCB1 or SMARCA4 expression in tumor cells are required for the diagnosis of atypical teratoid / rhabdoid tumor (AT / RT)
- Tumors with similar morphology and immunophenotype but that lack a classifiable mutation are classified as CNS embryonal tumors (not elsewhere classified [NEC]) or not susceptible to further analysis (not otherwise specified [NOS])
ICD coding
- ICD-O: 9508/3 - atypical teratoid / rhabdoid tumor
- ICD-11: 2A00.1Y & XH7ZQ4 - other specified embryonal tumors of brain & atypical teratoid / rhabdoid tumor
Epidemiology
- Accounts for 1 - 2% of all pediatric brain tumors and is very rare in adults (Front Oncol 2018;8:567)
- Age typically < 3 years; rare in children aged > 6 years (Neuro Oncol 2014;16:1392)
- Can occur in cerebral hemispheres, cerebellum or rarely in the spinal cord
Sites
- Cerebral hemispheres, cerebellar hemispheres, cerebellopontine angle, brainstem, spinal cord
- In adults, the most common sites are the cerebral hemispheres and sellar region
Pathophysiology
- Mutation or loss of the SMARCB1 locus at 22q11.2 is classic for this tumor (Nature 1998;394:203)
- Tumors with retained SMARCB1 can have biallelic inactivation and no expression of the SMARCA4 protein (Am J Hum Genet 2010;86:279)
- Function of SMARCB1 and SMARCA4 and their role in malignant transformation are unclear
Etiology
- Familial cases in the setting of rhabdoid tumor predisposition syndrome 1 (SMARCB1 gene) or 2 (SMARCA4 gene) (Acta Neuropathol 2014;128:453)
- De novo germline mutations have accounted for 66% of germline mutations (Pediatr Blood Cancer 2011;56:7)
Clinical features
- Depends on age and location
- In infants, lethargy, vomiting and failure to thrive are common symptoms (J Neurosurg 1996;85:56)
- If > 3 years, headache and hemiplegia are reported (Childs Nerv Syst 2009;25:707)
- Cranial nerve palsy (mostly sixth and seventh nerve paresis) may also be present
- Adult sellar AT / RT often presents with headaches, visual impairment and endocrine disturbances (Mod Pathol 2022;35:1910)
Diagnosis
- Diagnosis of AT / RT can be made on biopsy or cytology but staging requires cerebrospinal fluid (CSF) cytology (Radiology 1969;93:1351)
Laboratory
- No specific laboratory findings for this entity
Radiology description
- Isodense to hyperintense signal intensity on fluid attenuated inversion recovery (FLAIR) images with restricted diffusion
Radiology images
Prognostic factors
- Poor; 5 year progression free and overall survival rate is only 60%, even for the favorable group
- Clinical staging (Radiology 1969;93:1351)
Case reports
- 2 month old boy presented with rapidly increasing head circumference (J Pediatr Neurosci 2015;10:382)
- 2 year old boy presented with lethargy and vomiting (Asian J Neurosurg 2018;13:873)
- 23 year old man with an extra-axial dural based lesion (CNS Oncol 2020;9:CNS54)
- 55 year old woman presented with subarachnoid hemorrhage (Surg Neurol Int 2019;10:139)
Treatment
- Surgery, high dose chemotherapy with radiation (Pediatr Blood Cancer 2017;64:e26663)
Gross description
- Tan-pink to red soft tissue, appears demarcated from adjacent parenchyma
- Tumors with more mesenchymal tissue appear firm, tan-white
- Hemorrhage and necrosis can be seen (Autops Case Rep 2020;10:e2020205)
Frozen section description
- Sheets of eosinophilic, embryonal cells with round to oval hyperchromatic nuclei and minimal cytoplasm
- Rhabdoid cells are larger cells with eccentrically located nuclei and eosinophilic cytoplasm
Intraoperative frozen / smear cytology images
Microscopic (histologic) description
- Sheets of densely packed, immature cells with high N:C ratio
- Diagnostic feature on histology is the presence of cells with rhabdoid features, which includes (Neurooncol Pract 2019;6:163)
- Well defined cell borders
- Abundant cytoplasm with eosinophilic inclusions
- Eccentrically located nuclei containing vesicular chromatin
- Prominent eosinophilic nucleoli
- Mitotic figures can be numerous
- Geographic necrosis can be present
- Often diverse with a mixed histologic appearance (epithelioid, myxoid, spindled, chondroid) (Am J Surg Pathol 1998;22:1083)
- Primitive neuroectodermal component is most common (Am J Surg Pathol 2006;30:1462)
- Mesenchymal and epithelial features are less common
- Staghorn vasculature prominent in adult sellar AT / RT (Am J Surg Pathol 2017;41:932)
Microscopic (histologic) images
Contributed by Nirupama Singh, M.D., Ph.D., Chunyu Cai, M.D., Ph.D. (Case #502) and Geling Li, M.D., Ph.D.
Cytology description
- Embryonal cells with round to oval hyperchromatic nuclei and minimal cytoplasm
- Rhabdoid cells are larger cells with eccentrically located nuclei and eosinophilic cytoplasm
Positive stains
- Rhabdoid cells are positive for EMA, SMA and vimentin
- Cytokeratins, GFAP, NFP and synaptophysin staining are also observed
Negative stains
- Germ cell markers and skeletal muscle differentiation markers (MyoD1, myogenin)
- Nuclear loss of SMARCB1 (INI1) protein expression is highly sensitive
Electron microscopy description
- Rhabdoid cell cytoplasm
- Spherical, paranuclear, cytoplasmic inclusions
Molecular / cytogenetics description
- Loss of SMARCB1 (INI1) expression at the protein level is seen in most AT / RTs (Cancer Biol Ther 2009;8:412, Pediatr Dev Pathol 2018;21:6, Neuropathology 2018;38:305)
- Mutations in SMARCA4 (BRG1) gene are rare
- Loss of all or part of chromosome 22 is frequent
- Gene expression and methylation profiling identified 3 potential subgroups that can potentially aid in subgroup based therapies (Neuro Oncol 2020;22:613)
- ATRT TYR: overexpression of tyrosinase
- Whole or partial loss of one copy of chromosome 22 accompanied by a point mutation in SMARCB1 on the other allele
- Majority with infratentorial location
- Younger patient age (median age at diagnosis: 12 months)
- ATRT SHH: overexpression of sonic hedgehog and Notch pathways
- Most display compound heterozygous point mutations in SMARCB1
- Further subtyped by supratentorial (ATRT SHH1) or infratentorial (ATRT SHH2) localization
- ATRT MYC: overexpression of MYC oncogene
- Homozygous, broad loss of SMARCB1 with lower overall DNA methylation levels
- Older patient age (median age at diagnosis: 27 months)
- Adult sellar AT / RT: clinically distinct entity, however, DNA methylation is similar to ATRT MYC subgroup (Am J Surg Pathol 2018;42:506)
- ATRT TYR: overexpression of tyrosinase
Molecular / cytogenetics images
Sample pathology report
- Brain, suprasellar mass, biopsy:
- Atypical teratoid rhabdoid tumor (AT / RT), CNS WHO grade 4 (see comment)
- Comment: Sections of the suprasellar tumor demonstrate patternless sheets of malignant blue cells with round to oval nuclei, vacuolated chromatin and scattered inconspicuous nucleoli. Nuclear profiles are focally irregular. Tumor cells have variable eosinophilic cytoplasm. Scattered mitotic figures and apoptotic cells are noted. Microvasculature is prominent. Necrosis is not seen. INI1 nuclear immunoreactivity is lost in tumor cells.
Differential diagnosis
- Medulloblastoma:
- Larger, more atypical hyperchromatic nuclei
- Diffuse synaptophysin+
- Retained nuclear INI1
- Choroid plexus carcinoma:
- Rhabdoid meningioma:
- CNS embryonal tumors:
- Lacks rhabdoid inclusions
- Diffuse synaptophysin+
- Retained nuclear INI1
- Germinoma:
Practice question #1
Practice answer #1
B. Loss of expression of SMARCB1 or SMARCA4. SMARCB1 (INI1) is the most common and SMARCA4 (BRG1) is more rare (J Neurooncol 2020;150:47). Answer A is incorrect because a BAP1 mutation is not associated with this entity. Answers C and D are incorrect; although they may be seen in certain subgroups, they are not the key component of AT / RTs.
Comment Here
Reference: Atypical teratoid / rhabdoid tumor
Comment Here
Reference: Atypical teratoid / rhabdoid tumor
Practice question #2
Which of the following is the most common age range for presentation of an atypical teratoid / rhabdoid tumor (AT / RT)?
- 0 - 3 years
- 3 - 20 years
- 20 - 50 years
- 50 - 80 years
Practice answer #2
A. 0 - 3 years. > 80% of AT / RTs are diagnosed before age 3. Answer C would be correct for the primary adult sellar AT / RT. Answers B and D are not the most common age ranges for this entity.
Comment Here
Reference: Atypical teratoid / rhabdoid tumor
Comment Here
Reference: Atypical teratoid / rhabdoid tumor